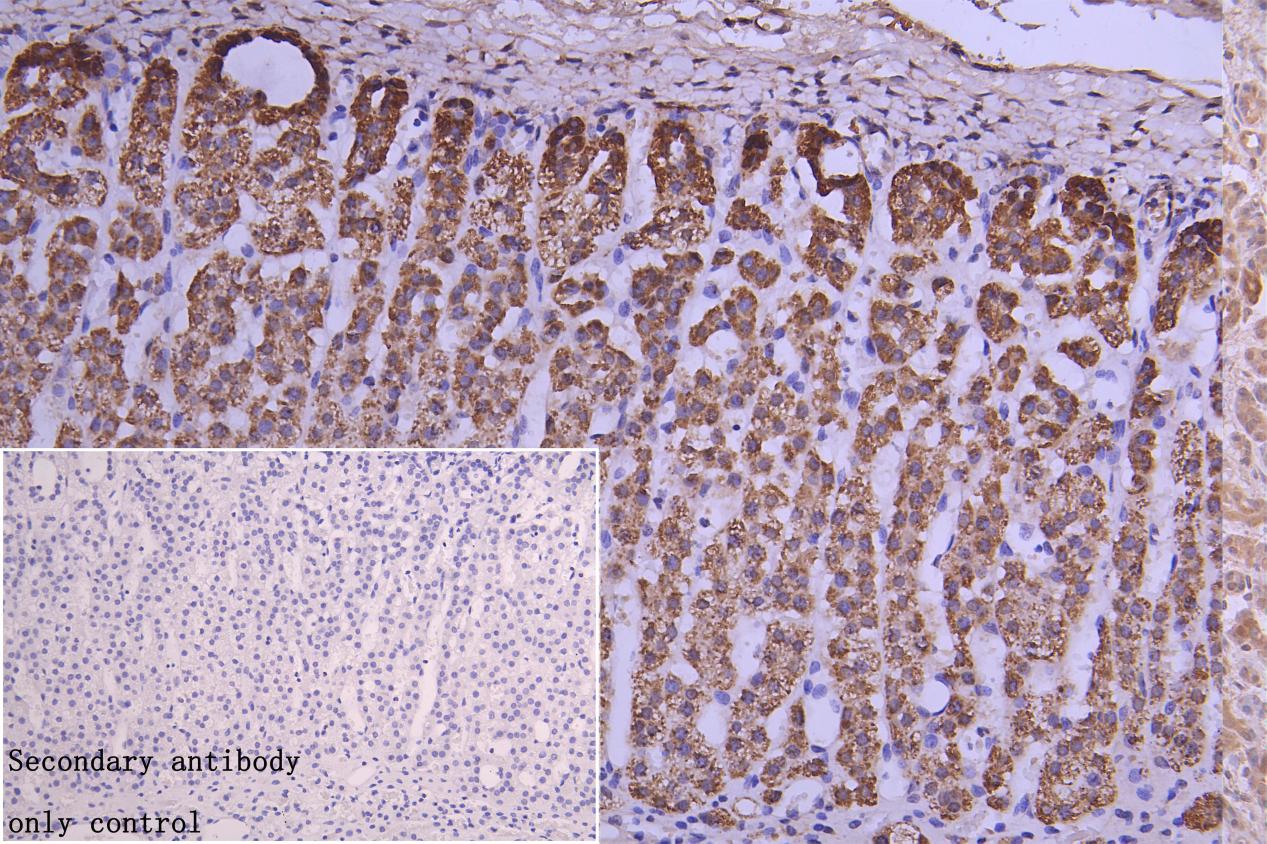

-
中文名稱:CRHR2兔多克隆抗體
-
貨號:CSB-PA623797LA01HU
-
規格:¥3900
-
圖片:
-
Western Blot
Positive WB detected in: Mouse Brain tissue lysate(20μg),Mouse skeletal muscle tissue lysate(20μg),Rat skeletal muscle tissue lysate(20μg),293 whole cell lysate(20μg), A549 whole cell lysate(20μg)
All lanes: CRHR2 antibody at 1:1000
Secondary
Goat polyclonal to rabbit IgG at 1/40000 dilution
Predicted band size: 48,51,46,45,43 kDa
Observed band size: 55 kDa
Exposure time: 120s -
IHC image of CSB-PA623797LA01HU diluted at 1:150 and staining in paraffin-embedded human adrenal gland tissue performed on a Leica BondTM system. After dewaxing and hydration, antigen retrieval was mediated by high pressure in a citrate buffer (pH 6.0). Section was blocked with 10% normal goat serum 30min at RT. Then primary antibody (1% BSA) was incubated at 4°C overnight. The primary is detected by a Goat anti-rabbit polymer IgG labeled by HRP and visualized using 0.05% DAB. Secondary antibody only control: uses 1% BSA instead of primary antibody
-
Immunofluorescence staining of Hela cell with CSB-PA623797LA01HU at 1:20, counter-stained with DAPI. The cells were fixed in 4% formaldehyde and blocked in 10% normal Goat Serum. The cells were then incubated with the antibody overnight at 4C. The secondary antibody was Alexa Fluor 488-congugated AffiniPure Goat Anti-Rabbit IgG(H+L).
-
Immunofluorescence staining of Hela cell with 5% goat serum, counter-stained with DAPI. The cells were fixed in 4% formaldehyde and blocked in 10% normal Goat Serum. The cells were then incubated with the antibody overnight at 4C. The secondary antibody was Alexa Fluor 488-congugated AffiniPure Goat Anti-Rabbit IgG(H+L).
-
Immunofluorescence staining of HepG2 cell with CSB-PA623797LA01HU at 1:20, counter-stained with DAPI. The cells were fixed in 4% formaldehyde and blocked in 10% normal Goat Serum. The cells were then incubated with the antibody overnight at 4C. The secondary antibody was Alexa Fluor 488-congugated AffiniPure Goat Anti-Rabbit IgG(H+L).
-
Immunofluorescence staining of HepG2 cell with 5% goat serum, counter-stained with DAPI. The cells were fixed in 4% formaldehyde and blocked in 10% normal Goat Serum. The cells were then incubated with the antibody overnight at 4C. The secondary antibody was Alexa Fluor 488-congugated AffiniPure Goat Anti-Rabbit IgG(H+L).
-
-
其他:
產品詳情
-
產品名稱:Rabbit anti-Homo sapiens (Human) CRHR2 Polyclonal antibody
-
Uniprot No.:
-
基因名:
-
別名:CRHR2; CRF2R; CRH2R; Corticotropin-releasing factor receptor 2; CRF-R-2; CRF-R2; CRFR-2; Corticotropin-releasing hormone receptor 2; CRH-R-2; CRH-R2
-
宿主:Rabbit
-
反應種屬:Human, Rat, Mouse
-
免疫原:Recombinant Human Corticotropin-releasing factor receptor 2 protein
-
免疫原種屬:Homo sapiens (Human)
-
克隆類型:Polyclonal
-
抗體亞型:IgG
-
純化方式:Antigen?affinity?purification
-
濃度:It differs from different batches. Please contact us to confirm it.
-
保存緩沖液:Preservative: 0.02% sodium azide
Constituents: 50% Glycerol, 0.01M PBS, pH 7.4 -
產品提供形式:Liquid
-
應用范圍:ELISA, WB, IHC, IF
-
推薦稀釋比:
Application Recommended Dilution WB 1:500-1:5000 IHC 1:20-1:200 IF 1:50-1:200 -
Protocols:
-
儲存條件:Upon receipt, store at -20°C or -80°C. Avoid repeated freeze.
-
貨期:Basically, we can dispatch the products out in 1-3 working days after receiving your orders. Delivery time maybe differs from different purchasing way or location, please kindly consult your local distributors for specific delivery time.
-
用途:For Research Use Only. Not for use in diagnostic or therapeutic procedures.
引用文獻
- Sini San ameliorates duodenal mucosal barrier injury and low-grade inflammation via the CRF pathway in a rat model of functional dyspepsia Zhu C, et al,International Journal of Molecular Medicine,2019
相關產品
靶點詳情
-
功能:G-protein coupled receptor for CRH (corticotropin-releasing factor), UCN (urocortin), UCN2 and UCN3. Has high affinity for UCN. Ligand binding causes a conformation change that triggers signaling via guanine nucleotide-binding proteins (G proteins) and down-stream effectors, such as adenylate cyclase. Promotes the activation of adenylate cyclase, leading to increased intracellular cAMP levels.
-
基因功能參考文獻:
- A non-coding CRHR2 SNP rs255105, a cis-eQTL for a downstream lincRNA AC005154.6, is associated with heroin addiction. PMID: 29953524
- CRF2 signaling induces alterations in both the epithelium permeability and the differentiation of human colonic carcinoma cell lines. PMID: 28811708
- Data show that corticotropin releasing hormone receptor 2 (Crhr2) protein is abundantly expressed in the heart, and plasma Ucn2 levels were higher in patients with heart failure compared to healthy controls, indicating that endogenous Crhr2 is associated with heart failure. PMID: 28550160
- Taken together, our data indicate that sex shows significant interaction with genotype and Ucn1 during colitis. Human duodenal and colonic biopsies revealed that sex-specific differences exist in levels of CRF receptors and Ucn1 expression in patients with CD compared with the matched non-IBD subjects. To conclude, Ucn1 mediates sex-specific immune and cellular signaling responses via CRF2, emphasizing the need for inclus PMID: 27053649
- Endogenous CRF may be involved in the pathogenesis of ischemia/reperfusion-induced enteritis, possibly via the activation of peripheral CRF receptor 2 PMID: 28011950
- This study showed that two CRHR2 variants (rs4722999-C and rs12701020-C) in BPD subjects with sexual and physical abuse. PMID: 26182893
- found associations between CRHR2 genotypes and haplotypes and negative emotion in IBS patients and controls PMID: 26808377
- Wound healing and signal transducer and activator of transcription 3 activity were elevated in CRHR2-overexpressing cells after urocortin 2 and IL-6 treatment, suggesting advanced healing progression PMID: 26597886
- This study demonstrated that CRF2 Receptor Deficiency Eliminates the Long-Lasting Vulnerability of Motivational States Induced by Opiate Withdrawal. PMID: 25672976
- D1 and CRF2 alpha receptors are capable of heterodimerization in living cells. D1 /CRF2 alpha receptor heteromerization might account, at least in part, for the complex physiological interactions established between dopamine and CRH. PMID: 25073922
- no difference in placental expression between intrahepatic cholestasis of pregnancy and controls PMID: 25172671
- not up-regulated by labor in placenta, fetal membranes, or myometrium PMID: 25426872
- HSF2 element confers estrogen up-regulation of CRHR2 transcription and estrogen increases CRHR2 transcription via induction of HSF2 demethylation. PMID: 24485608
- Results suggest CRHR-2 variants may affect risk for PTSD in women by attenuating the stress response and reducing symptoms of the disorder. PMID: 24123648
- The rate and extent of homologous CRF2(a) receptor desensitization is governed by agonist-specific mechanisms affecting G protein-coupled receptor kinase phosphorylation. PMID: 23820308
- CRFR2 antagonist astressin-2B abrogated the effects of UCN2 on VSMCs. In conclusion, UCN2 is significantly associated with AAA and inhibits VSMC proliferation by inducing a G1 cell cycle arrest suggesting a plausible regulatory role in AAA pathogenesis PMID: 24107226
- The down-regulation of the CRF2 receptor in the distal/sigmoid biopsies of ulcerative colitis patients is indicative of change in CRF2 signalling associated with the process of inflammation. PMID: 23539366
- Polymorphisms within CRHR1 and CRHR2 genes interacted with both childhood sexual abuse and emotional neglect to influence Iowa Gambling Task performance. PMID: 23177644
- Suggest that urocortin 1 increase LPS-induced endothelial permeability by disrupting the VE-cadherin-beta-catenin complex via activation of CRHR2. PMID: 23168683
- These findings reveal a complex interplay between the signaling molecules that allow "fine-tuning" of CRH-R2beta functional responses and regulate signal integration. PMID: 21338628
- nuclear translocation of Ucn along with the loss of CRFR2 in epithelial cells and microvasculature of tumoral specimens may be involved in the pathobiology of renal cell carcinoma PMID: 19437022
- Trophoblast cell cultures treated with increasing amounts of type 2 corticotrophin releasing hormone receptor mediate increased secretion of estradiol in the presence of androstenedione. PMID: 19417223
- Structural basis for hormone recognition by the Human CRFR2{alpha} G protein-coupled receptor. PMID: 20966082
- There is no significant difference between the expression of CRH-R2beta mRNA of preeclampsia and of normal pregnancies. PMID: 15924674
- Investigated whether a genetic variation in CRHR2 gene might be associated with preterm birth. The polymorphism does not increase the risk for preterm birth overall but might modulate the length of pregnancy in a dose dependent fashion in Caucasian women. PMID: 20164545
- Results suggest that the rs2267716 polymorphism in the CRHR2 gene might influence the risk of developing HCC in patients with HBV infection in Chinese population. PMID: 19813023
- data suggest a distinctive role for corticotropin-releasing hormone receptor 2 specific agonists like urocortin II in the control of myometrial contractility during human pregnancy PMID: 14592950
- The regions of the CRF2(a) promoter that regulate the inducible expression were determined PMID: 15331578
- ligand binding properties of CRFR2 PMID: 15652653
- expression by semiquantitative reverse transcriptase-polymerase chain reaction (RT-PCR) and fluorescent immunocytochemistry in umbilical cord blood-derived cultured mast cells PMID: 16326828
- CRHR2 polymorphisms examined do not confer susceptibility to panic disorder. PMID: 16691126
- Results demonstrate corticotropin-releasing factor (2) expression in the human gastric mucosa and indicate a physiological role of this receptor type in regulating apoptosis, an important parameter of gastric cell regeneration. PMID: 16972272
- results show that haplotype variation at the CRHR2 locus is associated with suicidal behaviour PMID: 17532191
- Human myometrium expresses both CRH-R1 and CRH-R2 during pregnancy. PMID: 17959885
- Association of corticotropin-releasing hormone receptor-2 genetic variants with acute bronchodilator response in asthma. PMID: 18408560
- UCN inhibited the proliferation and promoted the apoptosis of endothelial cells and down-regulated VEGF expression in vivo via CRFR2. PMID: 18443956
- Expression loss of CRFR2 in prostate cancer and its neovascularization contributes to prostate tumorigenesis, progression, and neoangiogenesis. PMID: 19058138
- receptors couple to different G-proteins in stably transfected human cells, leading to transient divalent calcium ion mobilization on top of the natural increase in cyclic AMP stimulation. PMID: 19098121
- the SCP/CRHR2 system is present in human ovaries and treatment with SCP/Ucn3 inhibits progesterone production by cultured granulosa-lutein cells through interaction with CRHR2 PMID: 19351656
顯示更多
收起更多
-
亞細胞定位:Cell membrane; Multi-pass membrane protein.
-
蛋白家族:G-protein coupled receptor 2 family
-
數據庫鏈接:
Most popular with customers
-
-
YWHAB Recombinant Monoclonal Antibody
Applications: ELISA, WB, IHC, IF, FC
Species Reactivity: Human, Mouse, Rat
-
Phospho-YAP1 (S127) Recombinant Monoclonal Antibody
Applications: ELISA, WB, IHC
Species Reactivity: Human
-
-
-
-
-